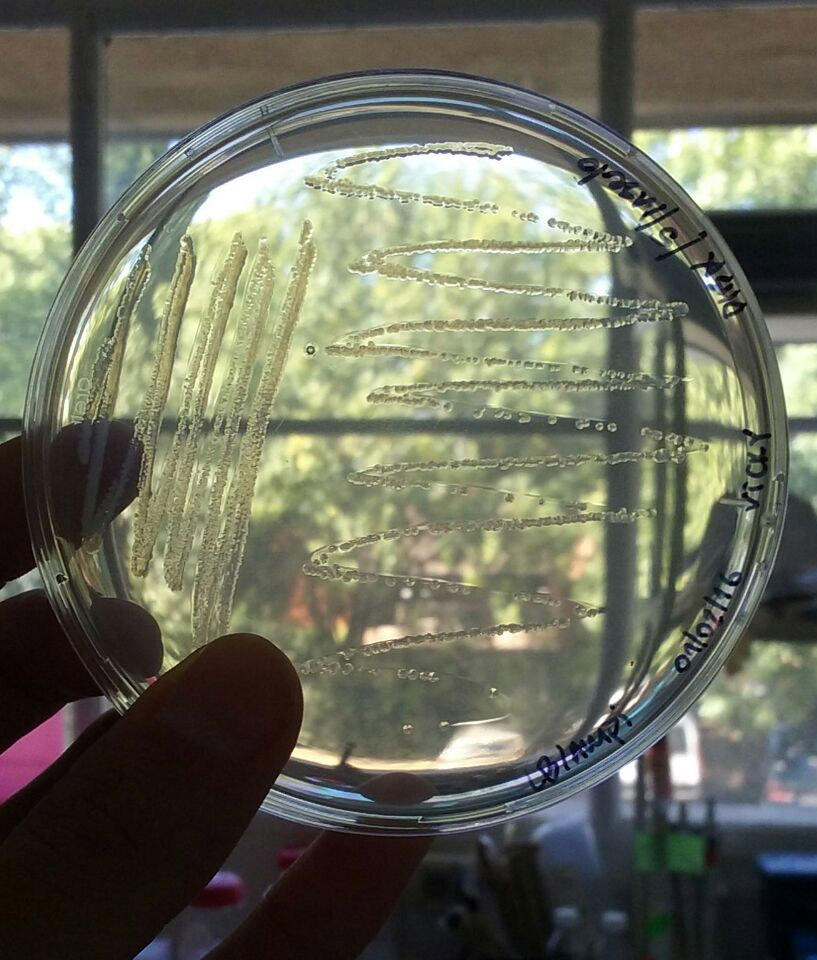
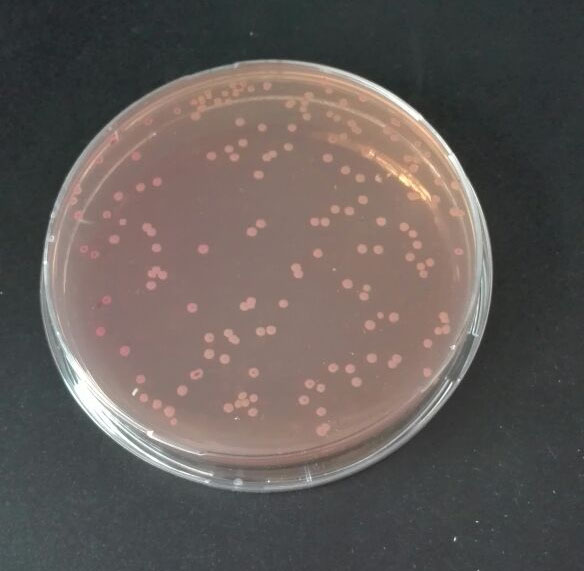

INSTITUTO DE HIGIENE
UNIVERSIDAD DE LA REPUBLICA
css3 menu by Css3Menu.com

Responsables: Lucía Yim y Laura Betancor. (Facultad de Medicina, Instituto de Higiene, UDELAR)
Fuente de financiamiento: CSIC, programa Grupos de investigación.
Nuestro grupo de investigación se focaliza en el estudio de las cepas de Salmonella que circulan en nuestro país. Esta bacteria es una de las principales causas de enfermedad transmitida por alimentos (ETA) en todo el mundo. Existen muchas variantes de Salmonella, que difieren en sus antígenos de superficie y en sus características genéticas. Algunas de estas variantes son mas capaces de diseminarse causando brotes de ETA, mientras que otras son mucho menos frecuentes como causa de infección humana, pero producen infecciones mas graves por lo que también resultan de interés para la salud. Nuestro trabajo intenta aportar en la comprensión de los factores bacterianos involucrados en estas diferentes capacidades, así como en las relaciones filogenéticas entre los distintos tipos de Salmonella circulantes.
Dado que la mayoría de los alimentos que se asocian a la transmisión de salmonella son de origen animal (aves y ganado vacuno entre otros), parte de nuestro trabajo se focaliza en el diseño de vacunas que protejan a los animales de producción de alimentos contra los tipos mas frecuentes de Salmonella.